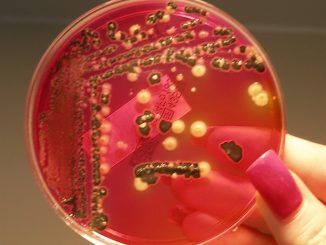

Resolved to lose weight in 2023? Experts compare popular diets
Losing weight is one of the most popular New Year’s resolutions—possibly to give yourself an excuse for some New Year’s […]
Losing weight is one of the most popular New Year’s resolutions—possibly to give yourself an excuse for some New Year’s […] Salmonella are food-borne pathogens that infect millions of people a year. To do so, these bacteria depend on a complex […] When conducting clinical research, investigators aim to control as many variables as possible so it is easier to examine the […] When children have autism, it’s possible to recognize the symptoms as early as when they are 18 months old. Although […] Rheumatoid Arthritis: NHS on common signs and symptoms We use your sign-up to provide content in ways you’ve consented to […] Christmas sex toy warning: Experts urge you to steer clear of chastity ‘cages’ and other utterly bizarre objects Thousands of […] It’s a cold and misty winter’s night. The sort of evening where most people want nothing more than to be […] The latest results from the Apple Women’s Health Study found 16.4% of the study population experienced abnormal uterine bleeding (AUB). […] Mawi’s Andrew Klymenko discusses silent heart attacks We use your sign-up to provide content in ways you’ve consented to and […] A Medscape report that explores how physicians prioritize substance abuse among leading American social issues also reveals their divergent views […]Health News

Resolved to lose weight in 2023? Experts compare popular diets
Researchers discover new role of small RNAs in Salmonella infections

Examining stroke treatment for people with disabilities

Look out for the early signs of autism

Eight at-home knee exercises to tackle arthritis this winter

The dangerous sex toys medics beg people not to use

The life-changing football league with more than one goal

Apple study: More than 16% experience abnormal periods

Comedian Ernie Wise suffered from two heart attacks before his death

Physicians React: Right Path Now With Pain Management, Opioids?
Copyright © 2026